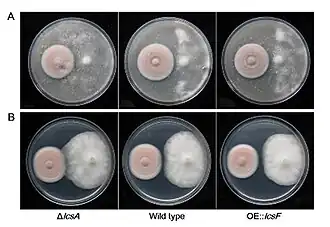

Purpureocillium lilacinum
| Purpureocillium lilacinum | |||||||||||||
|---|---|---|---|---|---|---|---|---|---|---|---|---|---|
| |||||||||||||
| Fialiden en lange ketens van elliptische conidia uit complexere vruchtstructuren die kenmerkend zijn voor Purpureocillium lilacinum; vergroting 460x | |||||||||||||
| Taxonomische indeling | |||||||||||||
| |||||||||||||
| Soort | |||||||||||||
| Purpureocillium lilacinum (Thom) Luangsa-ard, Houbraken, Hywel-Jones & Samson (2011) | |||||||||||||
| Afbeeldingen op | |||||||||||||
| |||||||||||||
Purpureocillium lilacinum is een schimmel behorend tot de familie Trichocomaceae. Sinds 2011 wordt de soort tot de familie Ophiocordycipitaceae gerekend. Het is geïsoleerd uit een breed scala aan habitats, waaronder beteelde en onbeteelde bodems, bossen, graslanden, woestijnen, estuaria-sedimenten, rioolslib en insecten. Het is ook gevonden in eieren van rondwormen en soms ook in vrouwtjes van wortelknobbelaaltjes en cystvormende aaltjes. Bovendien is het vaak aangetroffen in de rhizosfeer van veel gewassen. Purpureocillium lilacinum kan groeien bij een groot temperatuurbereik - van 8 tot 38 °C voor een paar isolaten, met een optimale groei tussen 26 en 30 °C. Het heeft ook een brede pH-tolerantie en kan op verschillende substraten groeien.
Beschrijving
Purpureocillium lilacinum vormt een dicht mycelium met conidioforen, waaraan de fialiden zitten. De kolonies op moutagar groeien vrij snel en hebben binnen 14 dagen bij 25 °C een diameter van 5 tot 7 cm. De basis van de kolonie is viltachtig met daar overheen in de lucht groeiende schimmeldraden. De kolonie is eerst wit, maar tijdens de sporenvorming verschillende tinten wijnrood. De onderkant is soms niet gekleurd, maar heeft gewoonlijk ook verschillende tinten wijnrood. De vegetatieve, gladwandige, doorzichtige schimmeldraden zijn 2,5 tot 4,0 µm breed. De conidioforen, die aan de half in de moutagar zittende schimmeldraden groeien, zijn 400–600 µm lang en die aan de in de lucht groeiende schimmeldraden zijn half zo lang. De fialiden aan de conidioforen hebben een gezwollen voet en lopen taps toe met een dunne, duidelijke nek. De ellipsoïde tot fusiforme Conidia zijn gladwandig tot iets ruw. De conidiën kiemen wanneer voldoende vocht en voedingsstoffen beschikbaar zijn. Chlamydosporeen ontbreken.[1]
Biologische bestrijding

Purpureocillium lilacinum kan ingezet worden bij de biologische bestrijding van rondwormen. Ze kunnen de eieren van wortelknobbelaaltjes infecteren en vervolgens verteren.[2] De schimmel vormt op het ei eenvoudige appressoria, hetzij nadat een paar schimmeldraden langs het ei-oppervlak groeien, of na een netwerk van schimmeldraden op het ei. Wanneer een schimmeldraad het ei is binnengedrongen, wordt de larve snelk gedood en na vertering worden er conidiën gevormd.
- ↑ Samson RA. (1974). Paecilomyces and some allied hyphomycetes. Studies in Mycology 6.
- ↑ Influence of egg parasitic fungus, Engyodontium aranearum against root knot nematode, Meloidogyne incognita. Journal of Applied and Natural Science 7 (1) : 124 –130 (2015)
